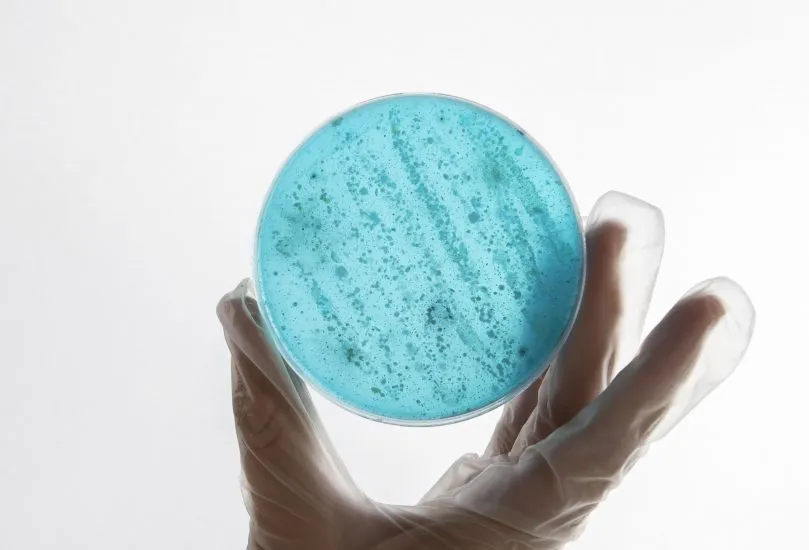
Recomendações do BrCAST-EUCAST para Controle interno de qualidade (CIM e Disco-Difusão)

Biblioteca
Escolha entre as opções abaixo:

Orientação do ICSH para testes de INR e dímero D usando testes POCT na atenção primária (tradução PNCQ)

Manual de Referência Técnica para a Higiene das Mãos
SALVE VIDAS, higienize suas mãos.
Recomendações do BrCAST-EUCAST para Controle interno de qualidade (CIM e Disco-Difusão)








